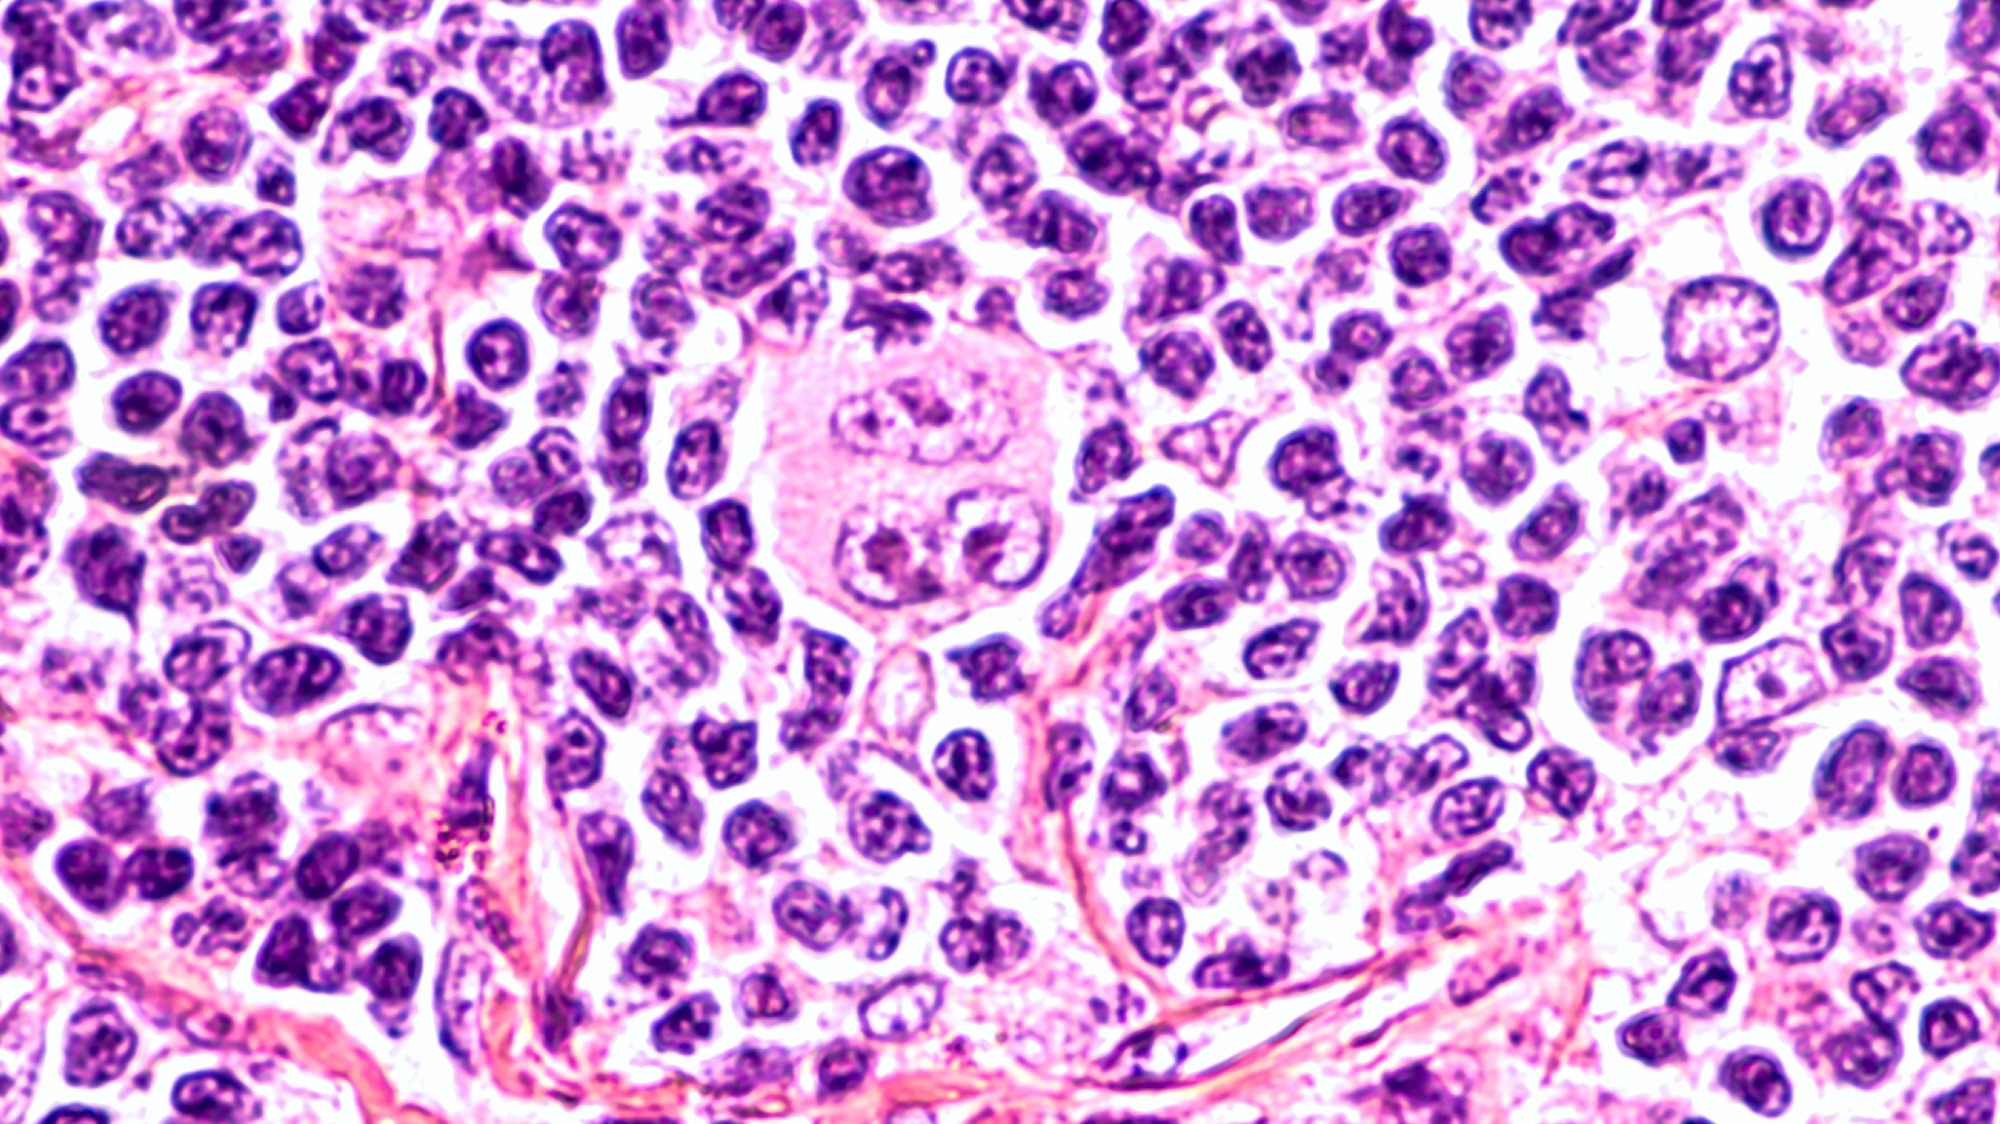
Photomicrograph of a lymph node in a patient with Hodgkin

Introduction
Epidemiology
Risk factors
HL types
Nodular Sclerosis Classical Hodgkin Lymphoma (NSCHL)
Mixed Cellularity Classical Hodgkin Lymphoma (MCCHL)
Lymphocyte-Rich Classical Hodgkin Lymphoma (LRCHL)
Lymphocyte-Depleted Classical Hodgkin Lymphoma (LDCHL)
Nodular Lymphocyte Predominant Hodgkin Lymphoma (NLPHL)
Diagnosis
Treatment
References
Further reading
Introduction
Hodgkin's lymphoma (HL), also referred to as Hodgkin's disease is a form of cancer that primarily affects the lymphatic system. HL generally starts in a lymph node and, in advanced cases, can spread to nearby lymph nodes and eventually invade different organs outside of the lymphatic system.
Photomicrograph of a lymph node in a patient with Hodgkin's Disease (lymphoma), showing a Reed Sternberg cell variant. Image Credit: David A Litman / Shutterstock
Photomicrograph of a lymph node in a patient with Hodgkin's Disease (lymphoma), showing a Reed Sternberg cell variant. Image Credit: David A Litman / Shutterstock
Epidemiology
HL accounts for about 10% of all newly diagnosed lymphoma cases in the United States, with non-HL accounting for the remaining 90%. Out of all newly diagnosed cancer cases in the U.S., HL has an incidence rate of about 0.5%.
HL is responsible for 5% of all lymphoma-related cases each year. Each year, this type of lymphoma causes about 0.2% of all cancer deaths in the United States. The incidence rate of HL is two to three cases for every 100,000 individuals worldwide, making it the most commonly diagnosed lymphoma.
Despite its relatively rare occurrence compared to other cancer diagnoses, lymphoma is the most common cancer diagnosed in adolescents between the ages of 15 and 19. HL has a disease peak in patients during their third decade of life and those over the age of 60. Men account for over 56% of new HL cases.
Risk factors
Several factors have been associated with an increased risk of HL. Identical twins, for example, are considered at an increased risk of HL, thus indicating the role of genetics in the pathogenesis of this disease. Additional genetic risk factors include several polymorphisms that have also been correlated with HL incidence.
About 45% of HL patients will also test positive for Epstein-Barr virus (EBV), with specific subtypes of HL more frequently associated with this virus than others. In addition, human immunodeficiency virus (HIV)-positive patients are also at an increased risk of developing HL.
In addition to the impact of certain genetic and viral components, socioeconomic status and other environmental factors also appear to increase the risk of developing HL.
HL types
HL can be categorized as either classical HL (cHL) or nodular lymphocyte predominant type Hodgkin's lymphoma (NLPHL). The distinction between either type of HL is based on microscopic evaluation involving the morphology and immunohistochemistry staining of affected lymph nodes and/or tumors.
Notably, cHL accounts for about 90% of all HL cases and can be further subdivided into four distinct subtypes. These include nodular sclerosis cHL (NSCHL), mixed cellularity cHL (MCCHL), lymphocyte-rich cHL (LRCHL), and lymphocyte-depleted cHL (LDCHL).
In cHL, tumor cells are primarily comprised of Reed-Sternberg (RS) cells that originate from mature B-cells. Despite this origin, RS cells typically appear much larger than B-cells due to the presence of multiple nuclei.
 Hodgkin's lymphoma. biopsy healthy human cells and lymphoma patient. Reed-Sternberg and other white blood cells. Image Credit: Designua / Shutterstock
Hodgkin's lymphoma. biopsy healthy human cells and lymphoma patient. Reed-Sternberg and other white blood cells. Image Credit: Designua / Shutterstock
Nodular Sclerosis Classical Hodgkin Lymphoma (NSCHL)
NSCHL is the most common type of cHL and accounts for about 70% of all cHL cases in developed nations. NSCHL is often characterized by neoplastic lacunar RS cells that are accompanied by a background of band-forming sclerosis.
Over 80% of patients with NSCHL will exhibit enlarged lymph nodes in the central part of their chest, with lymph nodes larger than 10 centimeters (cm) in diameter present in about 50% of NSCHL patients.
Mixed Cellularity Classical Hodgkin Lymphoma (MCCHL)
MCCHL is the second most common form of HL and accounts for 20-25% of cHL cases in the U.S. MCCHL is more frequently diagnosed in HIV-positive patients and those residing in developing nations.
Several different groups of lymph nodes are affected in MCCHL. RS cells in MCCHL are often present amongst lymphocytes, plasmocytes, histiocytes, and eosinophils without the co-expression of sclerosing fibrosis.
Previous infection with EBV is reported in about 75% of MCCHL cases. Although this subtype can affect any lymph node, it usually affects nodes in the upper extremities.
Lymphocyte-Rich Classical Hodgkin Lymphoma (LRCHL)
LRCHL accounts for about 5% of cHL cases. Upon microscopic analysis, LRCHL tumors consist of scattered HRS cells and small lymphocytes. Notably, neutrophils and eosinophils are not present in this type of tumor.
LRCHL tumors typically develop in the upper extremities, often leaving the mediastinal area unaffected. This subtype of cHL is associated with the most favorable prognosis when treated with modern combination chemotherapy approaches.
Lymphocyte-Depleted Classical Hodgkin Lymphoma (LDCHL)
LDCHL is the least common subtype of cHL and accounts for less than 1% of all HL cases in developed nations. On microscopic examination of lymph nodes, pleomorphic RS cells are abundant, with extensive fibrosis and few reactive lymphocytes known as reticular lymphocytes.
LDCHL is more likely to be at an advanced stage when diagnosed and often affects lymph nodes in the abdomen, liver, spleen, and bone marrow. In addition, the delayed diagnosis of these patients often correlates with a significantly worse prognosis as compared to other cHL subtypes.
Nodular Lymphocyte Predominant Hodgkin Lymphoma (NLPHL)
NLPHL accounts for about 5% of all HL cases, with CD20+, CD45+, CD30-, and CD15- malignant B lymphocytes predominant in these patients. The malignant cells of NLPHL tumors and affected lymph nodes will also exhibit a nodular growth pattern, with 'popcorn-life' lymphocytes and histocytes often identified in a fibrosis-free background.
NLPHL can occur at any age, although it is more common among older individuals than young adults. Furthermore, men account for about 75% of all new NLPHL diagnoses.
Diagnosis
The diagnosis of HL typically begins with the removal and histopathological analysis of a lymph node or biopsy of an affected organ. Patients will also undergo various imaging procedures, including contrast-enhanced computed tomography (ceCT) and fluorodeoxyglucose (FDG)-positron emission tomography (PET)-CT scans for staging.
HL staging
In addition to considering individual risk factors for HL, staging for this disease is achieved through a modified Ann-Arbor classification system.
- In Stage I, one lymph node or tissue outside the lymphatic system is affected.
- In Stage II, two or more lymph nodes on the same side of the diaphragm are affected, or localized involvement is detected outside of the lymphatic system.
- In Stage III, two or more lymph nodes or organs on either side of the diaphragm are affected.
- In Stage IV, HL has spread to at least one organ outside of the lymphatic system. Lymphoid tissues may or may not be affected in stage IV HL.
In addition to stages, HL stages could further be classified as categories, denoted by alphabets A, B, E, or S.
- A: B symptoms are not reported.
- B: B symptoms such as fever, over 10% loss of body weight in the past six months without dieting, and/or night sweats are present.
- E: HL has metastasized to organs or tissues outside the lymphatic system.
- S: HL cells detected in the spleen.
Patients with bulky nodes that exceed 10 cm in diameter, which is denoted by an X classification, may require more intensive treatment.
Treatment
Chemotherapy and radiation therapy are often combined to improve treatment outcomes for most types of HL. However, despite the efficacy of these treatment approaches, many of these agents are associated with significant toxicity that contributes to the long-term morbidity and ultimate mortality of HL patients. Some of the different adverse effects of these treatments can include bone marrow suppression, myelotoxicity, and impacts on fertility, depending upon the specific agent being used.
Combination chemotherapy has achieved impressive remission rates, particularly the mechlorethamine, vincristine, procarbazine, and prednisone (MOPP) approach, even among those with advanced cHL. Another notable combination regimen for HL includes Adriamycin (doxorubicin), Bleomycin, Vinblastin, and Dacarbazine (ABVD), which has achieved similar remission rates to that of MOPP. Notably, ABVD is associated with a better toxicity profile than MOPP, which has led this combination approach to be preferred over MOPP in the treatment of cHL in the United States.
Immunotherapy drugs, such as anti-programmed death-1 (PD-1) checkpoint inhibitors, may also be suitable for some HL patients. In addition, allogeneic stem cell transplantation (All-HCT) has also been shown to improve relapse-free survival rates.
Overall, HL is considered a highly curable type of cancer, with its five-year relative survival rate for patients with cHL ranging from 96.4% to 89.8% among those between 0-10 and 20-64 years of age, respectively.
Non Hodgkin's lymphoma | Spot it Early | Cancer Research UK
References
- Shanbhag, S., & Ambinder, R. (2019). Hodgkin Lymphoma: a review and update on recent progress. A Cancer Journal for Clinicians. doi:10.3322/caac.21438.
- Gopas, J., Stern, E., Zurgil, U., et al. (2016). Reed-Sternberg cells in Hodgkin's lymphoma present features of cellular senescence. Cell Death & Disease 7(e2457). doi:10.1038/cddis.2016.185.
- Hodgkin lymphoma [Online]. Available from: http://www.nhs.uk/conditions/Hodgkins-lymphoma/Pages/Definition.aspx
- Hodgkin Lymphoma [Online]. Available from: www.cancer.org/acs/groups/cid/documents/webcontent/003105-pdf.pdf
- Hodgkin Lymphoma Stages [Online]. Available from: https://www.cancer.org/cancer/hodgkin-lymphoma/detection-diagnosis-staging/staging.html
- Hodgkin Lymphoma Staging [Online]. Available from: https://www.lls.org/lymphoma/hodgkin-lymphoma/diagnosis/hodgkin-lymphoma-staging
- Types of Hodgkin lymphoma [Online]. Available from: https://www.cancerresearchuk.org/about-cancer/hodgkin-lymphoma/types
- Momotow, J., Borschmann, S., Eichenauer, D. A., et al. (2021). Hodgkin Lymphoma-Review on Pathogenesis, Diagnosis, Current and Future Treatment Appracohes for Adult Patients. Journal of Clinical Medicine 10(1125). doi:10.3390/jcm10051125.
Further Reading
Last Updated: Sep 20, 2022